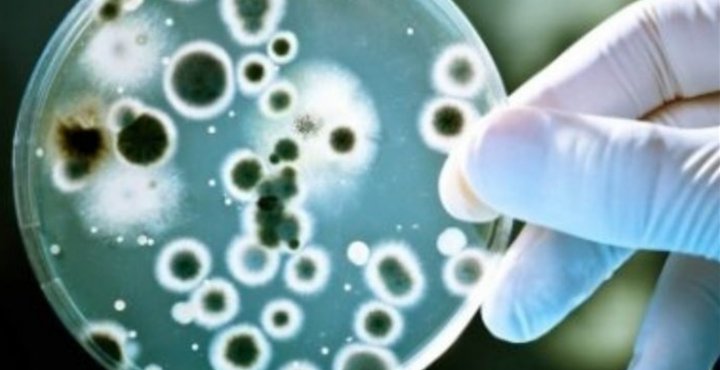

- Маєте запитання?
- (0332) 780293
- vpravda@gmail.com
В Україні виявили сибірську виразку
У Міністерстві охорони здоров’я України пояснили, як саме можна заразитися сибіркою, а також назвали симптоми при захворюванні. Зараження відбувається в результаті проникнення збудника через пошкоджену шкіру, слизову оболонку або укуси комах, повідомляється на сторінці Центру громадського здоров’я у Facebook.
У МОЗ розповіли про симптоми сибірської виразки. Також наголошується, що не виключена можливість зараження через контамінований збудником грунт або предмети.
При цьому від людини до людини захворювання не передається.
У ЦГЗ підкреслили, що середня тривалість інкубаційного періоду становить 2-3 дня, також можливі коливання від кількох годин до 14 діб.
Симптоми при захворюванні на сибірку
Хвороба начитається гостро. У перші ж години температура тіла різко підвищується до 38-40 градусів і виникає слабкість. Ділиться вона на кілька форм:
Сибірка на шкірі
- Сильний головний біль.
- Висока температура.
- Загальне нездужання.
- Карбункул з швидким наростанням набряку і свербіння.
Сибірка легеневої форми
- Сильні колючі болі в грудях.
- Задуха.
Сибірка кишкової форми
- Діарея з домішками крові.
- Ріжучі болі в животі.
- Блювота з домішкою крові.
У ЦГЗ закликають при найменшій підозрі на будь-яку з форм захворювання необхідна негайна госпіталізація. Сибірська виразка має важкий перебіг і може привести до смерті.
Як зменшити ризик захворіти на сибірку
У відомстві перерахували поради з профілактики інфікування:
- купуйте м’ясо та м’ясопродукти лише в місцях, де якість продуктів контролюють;
- люди, які переробляють та реалізують м’ясо чи будь-яку тваринницьку сировину, зобов’язані дотримуватися гігієнічних норм;
- виконання ветеринарно-санітарних правил під час догляду за тваринами;
- забій домашньої худоби лише з дозволу ветпрацівників;
- упорядковане захоронення трупів тварин;
- ветеринарний контроль хутряної та шкіряної сировини;
- контроль захворюваності тварин;
- знищення заражених трупів тварин;
- щеплення тварин проти сибірки;
- отримання особами, які мали контакт із хворими тваринами або сировиною, екстреної профілактики.

Більше читайте новин на нашому телеграм каналі та на сторінці у Facebook